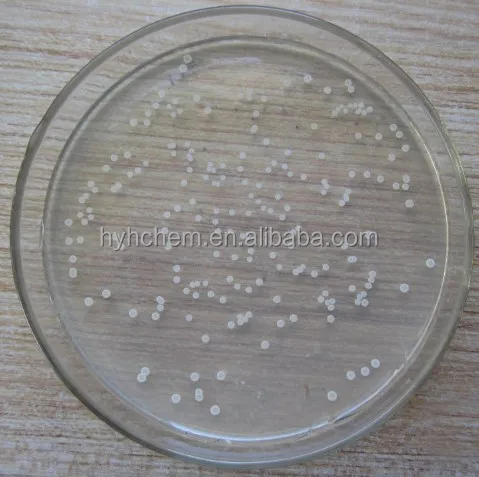
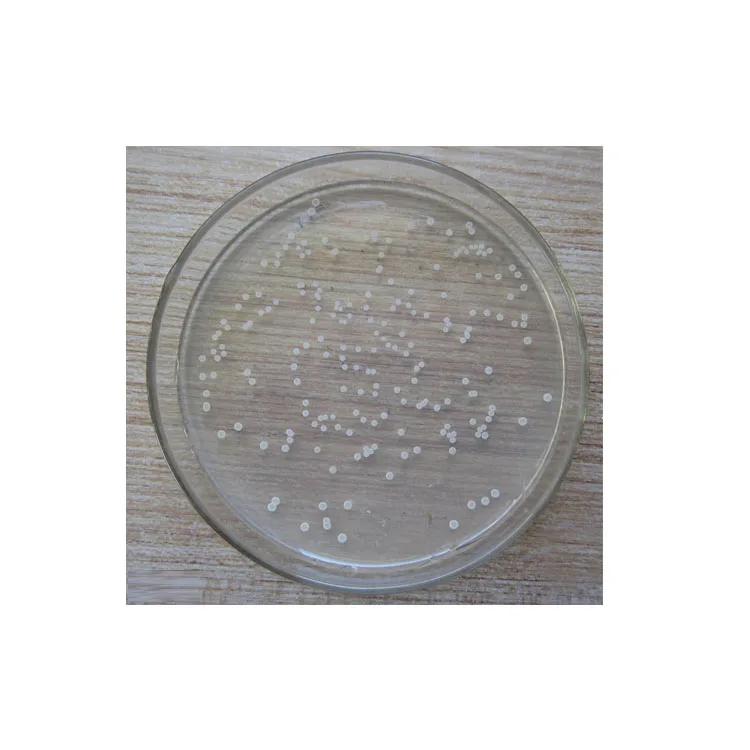
Биофунгицид Bacillus amyloliquefaciens, 6 миллиардов CFU/мл, жидкость для рисовой бактериальной болезни, бактериальная полоса листьев

Биофунгицид Bacillus amyloliquefaciens, 6 миллиардов CFU/мл, жидкость для рисовой бактериальной болезни, бактериальная полоса листьев
- Category: >>>
- Supplier: Henan Haoyuhang Economic&Trade Co. Ltd.
Share on (1600845981985):
Product Overview
Description
Product Name | Bacillus amyloliquefaciens |
Model | Strain Number AS 1.1099 |
Specifications | 200×10⁸CFU/g 1000×10⁸CFU/g 2000×10⁸CFU/g |
Appearance | Powder/granular/liquid |
Application 1 | Biological Fertilizer |
Application 1 | Fungicide |
Package | 1kg/25kg/customized |

Normally Package | ||
Liquid | 200L Plastic or Iron Drum. 20L, 10L, 5L HDPE, FHDPE, CO-EX, PET Drum 1L, 500mL, 250ml 200mL, 100mL, 50mL HDPE, FHDPE, CO-EX, PET, Aluminum Bottle, Shrink film, Measurement cap. | |
Solid | 25kg, 20kg, 10kg, 5kg, fibre drum, PP Bag, Craft Paper Bag, 1kg, 500g, 200g, 100g, 50g, 20g Aluminum Foil Bag, Soluble Bag. | |
The package can be made as the customer's requirement. | ||
Delivery | ||
Size | 12 (L) * 2.1(W) * 2.23m(D) | |
Weight | 20T | |
Delivery Details | The normal delivery by 20 or 40FT container shipping to the sea port in China according to customers special request. but we also has air fly shipping or express delivery service according to customers special request. | |


1,Q:How to start orders or make payments?
A:You can send our your Purchase order(if your company has), or just send a simple confirmation by email or by Trade Manager, and we will send you Proforma Invoice with our bank details for your confirmation, then you can make payment accordingly.
2, Q: How to confirm the Product Quality before placing orders?
A:You can get free samples for some products,you only need to pay the shipping cost or arrange a courier to us and take the samples. You can send us your product specifications and requests,we will manufacture the products according to your requests.
3,Q: What's your MOQ?
A:For the high value product, our MOQ starts from 1g and generally starts from 1kgs. For other low price product, our MOQ starts from 10kg and 100kg.
4,Q: Is there a discount?
A: Yes, for larger quantity, we always support with better price.
5,Q:How do you treat quality complaint?
A:First of all, our quality control will reduce the quality problem to near zero. If there is a quality problem caused by us, we will send you free goods for replacement or refund your loss.


We Recommend
New Arrivals
New products from manufacturers at wholesale prices